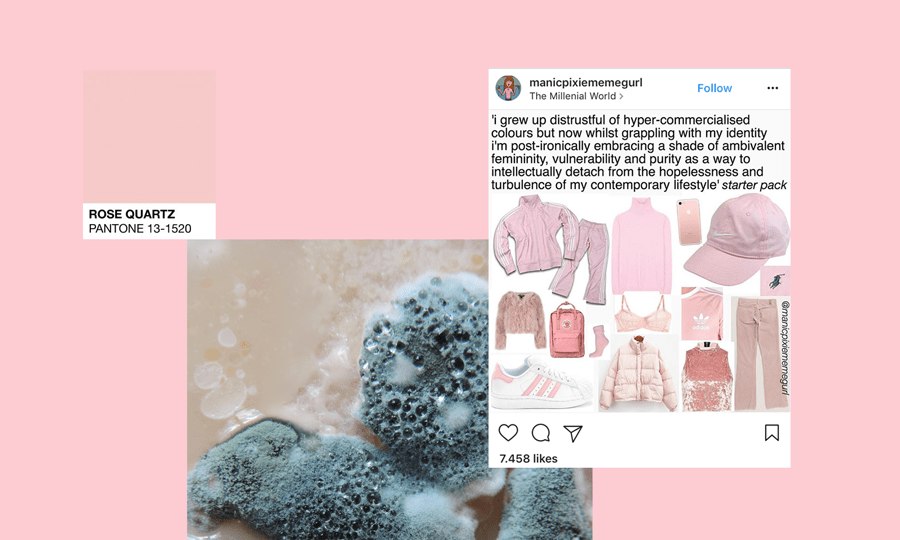

O ružičastoj
Što još razdvaja Federica Garcíju Lorcu i mene osim nasilne smrti, njegove bolje frizure i pjesničkog talenta? To da bi moji stihovi sigurno išli „Ružičasto, što volim ružičasto“, jer, kad se podvuče crta, za mene postoji samo jedna boja vrijedna diskusije, a to je ona – ružičasta; roza.
Prema svim bojama osjećam simpatiju ili antipatiju, ljubav ili mržnju, ali s rozom imam odnos. Odnos neumornog redefiniranja i preispitivanja moje vlastite žudnje za njom, koja se nekako nikad ne iscrpljuje, zbog koje mi sve ružičasto odmah djeluje bliskije, zamamnije, moje. Znam da u takvom odnosu nisam usamljena, da ga proživljavaju mnoge (i mnogi) i da se svi naši pojedinačni susreti s rozom događaju na pozadini njenog kompleksnog i burnog kulturnog položaja.
Nijedna boja, vjerujem, nije toliko dubinski politična kao roza. Osim crvene i bijele, u njoj se neodvojivo miješaju ionako nerazdvojni patrijarhalni i kapitalistički modusi oblikovanja ženskosti. Ružičasta tako stoji na križanju želja i otpora koji definiraju suvremenost: želje za rodom i otpora rodu, želje za potrošnjom i otpora potrošnji, posjedovanju, ili ugrubo – kapitalizmu.
Ovo je stoga jedan pogled na rozu, vjerojatno najomraženiju i najmanipulativniju boju koju znamo, moju mezimicu.
ROZA KAO ROZA
Kad govorim o ružičastoj mislim na sve nijanse na koje bi neka koloristički nemarna osoba pokazala i kliknula „Roza!“ (osim nijansi ljubičaste s kojom bi je možda pomiješala). Prihvaćam i ne diskriminiram; ja sam blagi pastir, a one moje stado: amarant, hot pink, fuksija, fandango, boja lososa, žarkoružičasta, barbie, perzijska, ili pak #FF0066, boja Mufa.
Unatoč bogatstvu njenih nijansi, asocijacije i mentalni koncepti koje u suvremenoj zapadnoj kulturi vežemo uz sve rukavce roze boje slijevaju se u jedan konačni pojam: ženskost. Veronika Koller provela je istraživanje o korištenju i doživljaju roze na 169 ispitanika te od rezultata strukturirala semantička polja, odnosno ocrtala značenja koja joj najčešće pripisujemo.1 Uz neke iznimke, kao što su požuda i neovisnost, radi se o orodnjenim konceptima koji sa sobom vuku uteg ženskog, poput nježnosti, nevinosti, romantike i mekoće.
Roza je na zapadu nedvosmisleno boja ženskosti, ali potpuno se slažem s Thomasom von Taschitzkijem koji tvrdi da „sadrži, generira i tolerira više kontradikcija od praktički ijedne druge boje“.2 Ne radi se samo o tome da istovremeno može biti požudna i nevina – svaka od njenih pozitivnih „femininih“ asocijacija nabijena je potencijalom da se izvrne u vlastitu negaciju: zagušujuću nježnost, morbidnu romantičnost, mazohističku mekoću. Možda je vidimo kao princezu u staklenim cipelicama, ali ružičasta je boja na staklenim nogama, uvijek sposobna razlomiti se na zaoštrene komadiće. To je i prvo ključno mjesto rasprave o njoj.
Drugo je njena omraženost – kao što Koller otkriva, samo ju je 7,7% anketiranih izdvojilo kao omiljenu boju, dok je 10,1% najmanje draga; nije bila najdraža niti jednom muškarcu, ali bila je najmrža svakom petom. Prema Evi Heller,3 od nje je manje popularna jedino smeđa, boja blata, dosade i izmeta.
Vjerujem da su obje stvari posljedica politike upisane u rozu; jednom kad joj je srž postala ženska, iz te su koštice morale proklijati nevolje. Roza je srasla sa svojom ženskošću, što znači da je priča o njoj priča o patrijarhatu i mizoginiji, o nemogućem rodu, o dijeljenju ljudi u kućice i građenju ograda među njima. A s ogradama ću i početi.
ROZA KAO OGRADA
Svi smo već čuli tu začudnu istinu – do kraja 19. stoljeća boja dječje odjeće bila je uniseks bijela, a onda su djevojčice počeli odijevati u plavo, a dječake u roza. Zašto? Kako bi ih se naučilo da su različiti, jer vremena su se mijenjala i djevojčice su imale sve veću slobodu ponašati se slobodno kao dečki. Obojane su tkanine trebale takvim aspiracijama stati na kraj, i instruirati: rod je hijerarhija razlika; roza nije plava, dječak nije djevojčica. Plava je tad, kao „nježnija i ljupkija“, bila primjerenija za ženskost, a roza, „bliski rođak crvene“, za hrabru i odlučnu muškost.4
Podjela se obrnula nakon 1940-ih, a od ’80-ih se primjenjuje s rigoroznošću zakona, kao što potvrđuju knjige i tekstovi na tu temu, ili kretanje kroz svijet s minimumom svijesti. Feminizam je izvojevao mnoge pobjede i rodna je ravnopravnost generalno sve veća i robusnija, ali taj je napredak pod stalnim napadom, i polarizacija istisnuta iz svijeta odraslih preplavljuje prostor djetinjstva (odjeću, igračke, knjige, bočice, pribor za jelo, a nekad i jelo). Koloristička ograda koju postavljamo između tzv. ženske i muške djece služi, očito, njihovu razdvajanju, nadziranju i discipliniranju, te fetišiziranju ženskosti od malih nogu. Različit kulturni tretman boja iz te binarne opreke zrcali različit društveni tretman rodova.
Plava je redovita pobjednica izbora za najpopularniju boju na svijetu. Iako označava muškost kad je postavljena nasuprot rozoj, to ni približno nije njena primarna ili definirajuća kvaliteta. Odrasli muškarci i žene mogu se odijevati u plavo bez negativnih konotacija. Plava je boja mora, neba, Zemlje; svih prostranstava koja znamo. Plava je univerzalna. Roza, s druge strane.
Roza je partikularna, od latinskog particula: mali dio, komadić; taman toliko sitna da stane u stisnut dječji dlan. Dok sam odrastala, mnogo je djevojaka a onda i žena oko mene mrzilo rozu – možda su se bojale da bi se mogle okužiti njenom naivnošću, slabošću, i ostalim negativnim epitetima. Rozu nose djevojčice, jer su slabe, ili je roza slaba jer je nose djevojčice? Svejedno. Mislim da monopol roze služi tome da označimo djecu koju odgajamo kao žensku, te da ona vide i prepoznaju tu boju kao svoju, da prihvate njeno značenje – (svoju) ženskost – i nauče da je ona nešto izvanjsko. Izvanjsko – ono usmjereno na vanjštinu, ali i ono što je izvan; ne baš u našoj moći, ne baš pod našom kontrolom. Jer u jednom trenutku, negdje na početku puberteta, iz razloga koji ne potječu iz nas, roza postaje neprikladna, sramotna, pogrešna (tako je bar bilo do prije nekoliko godina, otkad je moderna). Dijelom jer više nismo djeca, a ona je dječja, dijelom jer smo sad djevojke, a ona je djetinjasta ženskost. Ženskost se onda otkriva kao nešto što nam uvijek izmiče i mijenja se, što treba naučiti kontrolirati; jer postoje pravila, i točno i pogrešno, i posljedice. Nekad je ženskost sobičak ružičastih zidova, u kojem se osjećaš bespomoćno.
A s druge strane ograde: otvoreni horizont, plavo dokle oko vidi.
ROZA KAO TRIK / ROZA KAO ORUŽJE
Roza, naravno, služi i tome da nam prodaju stvari.
Koller u svojoj studiji zaključuje da je „prva i osnovna funkcija [roze] denotirati nešto kao feminino“. Neću trošiti vrijeme na sve proizvode koji su poružičastili kako bi bili prikladni za žensku populaciju – od žitarica, preko čepića za uši i Kinder jaja, do laksativa – makar me zanima koliko je zaista profitabilno takvo nepotrebno orodnjavanje robe.
Ne, posvetit ću se situacijama u kojima je roza paravan za brigu, pažnju, nježnost, zdravlje ili dobrotu, dok se iza zastora krije vrlo trezvena kapitalistička operacija maksimalne isplativosti. Od najpoznatije je instance korištenja roze kao trika potekao i termin „pinkwashing“. Za one koji ne znaju, „pinkwashing“ je originalno označavao aktivnosti kompanija koje se predstavljaju kao angažirane u borbi protiv raka dojke, dok istovremeno profitiraju od te bolesti i prodaju proizvode koji povećavaju rizik od njenog dobivanja. Danas ga vjerojatno češće koristimo kad govorimo o prikrivanju problematičnih politika glasnim podržavanjem LGBTIQ populacije.
Kampanja „Think Before You Pink“, koju je pokrenula inicijativa Breast Cancer Action, poziva kupce da kritički pristupaju proizvodima i akcijama s poznatom ružičastom trakom, simbolom svijesti o raku dojke. „Više od 30 godina nakon početka pokreta za podizanje svijesti o raku dojke i uvođenja ružičaste vrpce, rak dojke i dalje je zdravstvena kriza i pitanje društvene pravde. No, mainstream pokret protiv raka dojke čvrsto je fokusiran na ružičaste vrpce, kampanje podizanja ‘svijesti’ i mamografske preglede. Tako se ne uspijevaju adresirati sistemski problemi koji su u srcu ove epidemije, već se naglasak stavlja na individualni rizik i individualna rješenja.“
Kao što Audre Lorde piše u Dnevnicima raka, individualni napori i osobna sreća ne mogu nas „zaštititi od rezultata ludila za profitom“5, jer je po zdravlje žena i šire populacije pogubno upravo djelovanje kapitalističkog sistema. Samantha King opisuje kulturu pobjede nad rakom dojke u Americi kao „pro-žensku, ali ne feminističku, osnaženu, ali ne ljutitu, sestrinsku, ali ne kolektivnu, i potpuno rastavljenu od pitanja povezanih sa seksualnim identitetom, rasom ili klasnom dinamikom“.6 Ružičasta odvlači pažnju s toga uglačanim smiješkom, i krišom mete stvarnost raka pod homogeni, pastelni tepih.
Ali ljudi smo, pa stvari uvijek mogu biti grotesknije.
Mjesec svijesti o raku dojke, listopad, lani su između ostalih obilježile i američke te izraelske oružane snage. Kako? Kako drugačije nego ružičastim borbenim zrakoplovima! Jer ništa ne govori „život je dragocjen“ kao stroj za njegovo uništenje. Kao što je lijepo dočarala Christina Cauterucci, „[l]etjet će nebom, uništavajući tumore i manjak svijesti svojim raketama, sijući rozu smrt i rozu destrukciju i roze civilne žrtve i roze izbjegličke krize i roza uništenje kulturne baštine kamo god ih odvedu njihovi plemeniti, o raku osviješteni piloti“.
Kapitalistička praksa korištenja roze kao trika ovdje se glatko stapa s političkom praksom korištenja roze kao oružja. U prolazu ću vas podsjetiti i na hrvatsku predsjednicu Kolindu Grabar-Kitarović, koja često odijeva rozu u blizini vojske i na diplomatskim misijama. Roza, koja naglašava predsjedničinu ženskost, ulazi u zanimljivu komunikaciju s njenom militarističkom desnom politikom. No, kad govorimo o rozoj kao oružju, najmračnija je i najpoznatija njena upotreba iz Drugog svjetskog rata.
U nacističkim koncentracijskim kampovima obrnuti trokut ružičaste boje bio je oznaka za identificiranje gej muškaraca. Zatvorenici s ružičastim trokutom bili su na dnu društvenog sustava u kampovima, i trpjeli, čak i u ovim ekstremnim uvjetima, posebno okrutan tretman.
LGBTIQ aktivisti u ’70-ima su obrnuli, odnosno uspravili rozi trokut, i uzeli ga pod svoje. Bio je najpoznatiji simbol gej ponosa do početka ’90-ih, kad je primat preuzela dugina zastava. U jeku epidemije side, 1987., šest gej aktivista iniciralo je plakatiranje New Yorka posterom na kojem je trokut stajao iznad natpisa „SILENCE = DEATH“. Istoimeni projekt u svom manifestu vuče paralelu između nacističkog perioda i krize AIDS-a za vrijeme Reaganove administracije, te inzistira da „tišina o opresiji i uništenju gej ljudi, tada i sada, mora biti prekinuta kako bismo preživjeli“.
Upravo je crvena vrpca, simbol svijesti o sidi, bila ona koja je pokrenula lavinu vrpci raznih boja i namjena, no ružičasta ju je debelo nadmašila svojim uspjehom i korporativnom popularnošću. King piše kako je već spomenuto brisanje svih odnosa moći koji su u pozadini epidemije raka dojke vodilo do toga da njegovo lice, i lice pobjede nad njim, bude ono bijele (cis) ženskosti, najnevinije moguće žrtve. Sidu je američka vlast ignorirala zbog institucionalizirane homofobije; njene se žrtve doživljavalo kao devijantne, moralno posrnule ljude, koji se ne bi razboljeli da su vodili ispravne živote. Jasno je koja je bolest marketinški sigurniji izbor.
Područje LGBTIQ prava ozbiljna je bojišnica ružičaste, gdje za njom posežu i anti-LGBT snage i LGBT aktivisti. Sjetite se samo Željke Markić i njenih ranih medijskih istupa. Fotografije Markić u ružičastom kompletu, dok pored nje sjedi Zlatko Hasanbegović, ikonične su slike borbe protiv ljudskih prava u Hrvatskoj. Logo U ime obitelji, (plagirana) ilustracija hetero obitelji s dvoje djece, majku u tom paru obilježava očitom ružičastom. Sasvim je jasno da rozu koriste uzimajući njeno prvo značenje, i rabeći ga potpuno doslovno, kao marker valjane ženskosti i zdrave binarne podjele na Muški i Ženski rod (hetero orijentacije). Roza je u takvim rukama oružje jedne istine, jedne ideološke čistoće, bez nijansi. Ali, to naprosto nije njena priroda.
S druge je strane bojišta roza kao boja kiča, campa, draga, i drugih kvir praksi svjetotvornog izvrtanja značenja. Proteže se LGBTIQ zastavama – od trans zastava, preko biseksualne, panseksualne, androgine, interseksualne, do one genderfluid – gdje označava ženskost, ali ženskost koja nije monolitna, jednoznačna datost. U kosi i na tijelu Marshe P. Johnson, to je ženskost za koju se bori vlastitim životom. Toj rozoj nije stran otvoreni sukob: u New Yorku je ’70-ih pokrenut i Pink Panther Patrol, grupa koja je noćima patrolirala gradom kako bi gej ljude štitila od nasilja (logo im je rozi trokut s otiskom šape).
Ključna je razlika ovo: u rukama LGBTIQ borkinja, roza nije samo oružje za uništenje neprijatelja, nego i oruđe za izgradnju dobrog života.
ROZA KAO EKSCES
Zbog natopljenosti shizofrenim značenjima, pojavljivanje roze može uznemiriti više od pojavljivanja drugih boja; poput platipusa, sama je po sebi poremećenija od ostalih. Nekad se taj potencijal idealno poklopi s njenim korištenjem. Na primjer, stanovita Miljana Kulić, sudionica nekoliko reality showova na srpskoj televiziji, rozom se poslužila u raljama ljubavne opsesije pjevačem Mišelom Gvozdenovićem. Miljana je Mišela opsjedala bar pet godina, a u jednom mu je trenutku kuću i psa obojala u roza.
„Kupila sam farbu, tonere, merdevine, sve potrebno i dovezla sam se taksijem ispred njegove kuće. Radila sam u Čačku u jednoj kafani i sav novac sam trošila na taksi, koji bih plaćala da me vozi oko njegove kuće“. Kući se prišuljala u noći, a Mišelov pas pustio ju je da u miru farba jer ga je već danima potajno hranila.
“Prišla sam normalno, pas mi se obradovao. A za njega sam pripremila kolor šampon. Kad sam ga ofarbala, bio je kao Zorica Brunclik”.
Iz Mišelovog se nabrajanja Miljaninih postupaka otkriva da operacija Zorica Brunclik možda nije prošla tako glatko. „Roditelji mi iz Holandije dođu na mesec i po u Čačak, a ona ih dočeka i isprati pred kapijom, gde stalno stoji. Majku mi je dva puta udarila. Slala mi je vatrogasce i hitnu pomoć na adresu, bacala petarde, napravila poplavu u dvorištu i mazala psa ko zna čime, pa je uginuo. Čitavu noć se vozi taksijem oko kuće i u pet ujutro počne da viče: ‘Cigani, izlazite! Jebaću vam mater’.“
Zvuči spektakularno, ali Miljanino ponašanje nije nimalo bezazleno – radi se o opsjedanju, uznemiravanju i zlostavljanju koje srpske vlasti ne shvaćaju ozbiljno ili ne znaju riješiti, kao i u uobičajenim, rodno izvrnutim situacijama, oslanjajući se na pogubne stereotipe o ljubavi i rodu. Ono je prekoračenje svake mjere prihvatljivog ponašanja i iskazivanja osjećaja. Istovremeno, bojanje u roza logično je – Miljanina je ljubav tolika da može progutati pse i kuće, to je ljubav koja mora ostaviti vanjski trag, a roza je boja nježnosti i romantike, kao i boja ekscesa. Roza uvijek ima potencijal da istovremeno bude i neprimjerena i prikladna, i manipulativna i iskrena, i nježna i nasilna. Kao boja s viškom značenja, roza je eksces sama po sebi.
Čvorište roze, ljubavi i preobilja potpuno je utjelovila engleska spisateljica Barbara Cartland, ljubiteljica torijevaca i pekinezera. Takozvana kraljica romansi napisala je 723 objavljena i 160 neobjavljenih romana, a u starijim se danima odijevala od glave do pete u ružičasto. To je poklapanje gotovo presavršeno; čak i da je fikcionalan lik, njena bi potpuna posvećenost ljubavi, pisanju o ljubavi, i rozoj mogla djelovati pretjerano.
Zapravo i postoji lik koji kao da je temeljen na Cartland, a pojavljuje se u romanu Fey Weldon The Life and Loves of a She-Devil. U ekranizaciji, filmu She-Devil, Meryl Streep glumi lik kraljice romansi u koju se zaljubljuje suprug glavne junakinje Ruth (Roseanne Barr). Mary Fisher živi u ružičastom dvorcu s ružičastim sobama, odjevena u ružičaste haljine i kompletiće, te piše ljubavne romane na ružičastoj pisaćoj mašini. Njena afera s Ruthinim suprugom Bobom uključuje različite romantične trope, od razbijanja čaša u kaminu i prepuštanja strastima pred istim, do zaklinjanja na ljubav na okruglom, ružičastom krevetu. Drugim riječima, Mary Fisher zaista živi život svojih junakinja, bar do trenutka kad, Ruthinim angažmanom, u njega uđe malo previše stvarnosti. Kad se u dvorac usele antipatična Bobova djeca, Maryna nemilosrdna majka i gomila stvari koja zatrpava ružičasti dekor (Playstation! satelitska antena! prljava roba!), fantastični lik Mary Fisher počinje kopniti, a zamjenjuje ga umorna i iživcirana žena silom usidrena u zbilji. Njen je novi roman fijasko, jer se umjesto sladostrašćem bavi dosadnom kućanskom ljubavlju, a nesretno joj ugine i pudlica. Promjena se poklapa s hlađenjem Bobovih osjećaja i njegovom aferom s tajnicom, a završava izdanom i u ljubavi razočaranom Mary Fisher, koja se više ne odijeva kao izmaštana heroina. Njena nas priča uči da ljubavni odnos ne može dugo trajati kao fantazija, koliko god savršena ta fantazija bila – u fantazijama živjeti možemo jedino sami, kao što je Mary Fisher živjela, a stvarnost druge osobe donijet će nered, veš i razočaranja.
Ružičasto + eksces = inherentni eksces ružičaste intenzivira ostalu ekscesivnost situacije. Zašto bi itko bio ili činio takav eksces? Možda je to način utvrđivanja vlastitog mjesta. Pozicionira nas u svijetu tako da iz njega stršimo, da drugi vide da postojimo. U jednu je ruku hrabar, jer mnogi koji bi to htjeli nemaju odvažnosti stršati kao Barbara Cartland. U drugu nas razotkriva kao one koji vjeruju da će nas fantazije koje ispletemo oko sebe na neki način zaštititi, kao Mary Fisher. Ili govori o nekim većim i za sve uključene bolnijim nemogućnostima da stvarnost razdvojimo od te fantazije, kao kod Miljane Kulić. Rozi eksces – način da se pojavljujemo u svijetu, „latice na mokroj, crnoj grani“, ali i način da svima pokažemo svoje bolno, ružičasto tkivo, svoju ranu.
ROZA KAO UŽITAK / ŽUDNJA
Iz te senzacije poremećenosti – pomaknutosti, uneravnoteženosti – proizlazi jedan od užitaka roze. Prigrljujem rozu zbog njene histerije, ali taj je zagrljaj intimniji nego što se čini – nestabilnost roze zrcali moju vlastitu nestabilnost, zbog čega mi je roza i oslonac, izvor stabilnosti. Koristim rozu da me učvrsti, kao komad presavijenog papira ispod noge stola. Naša dva minusa možda daju plus, a možda znak jednakosti, gdje roza = ja. Roza, moja prijateljica, moj užitak, moj užitak u sebi.
Uživam kaleidoskopski i u stvarima koje se lome, tamo gdje se prelamaju iz jednog u drugo značenje, otklizavaju, razdvajaju i spajaju. Ružičasta je na takvim mjestima sto posto prirodno – pojavljuje se tamo gdje se ljudska tijela rastvaraju ili otvaraju, na ulazima i izlazima; pojavljuje se na šavovima dana, između noći i jutra, između dana i mraka. Užici i roza i stvari koje su skliske; užici i roza = stvari koje su skliske.
„Sklisko mjesto“ prijevod je jidiške riječi „glitsh“, izglednog etimološkog izvora riječi glitch. Glitch je kratki krah u modernoj tehnologiji, slikoviti trenutak poremećaja. Neki moji užici – bizarne situacije među osobama na ulici, stihovi koji mi stalno uskaču u misli kao nečiji urok, veliko gumeno ljudsko srce otrovnog mirisa – imaju auru nasumične ćoravosti glitcha. Uživanje je u tome što sa stvarnosti podižu njen mirni poklopac i otkrivaju crve; pravu, migoljavu prirodu svijeta, ali samo na čas.
Jenny Sundén tvrdi kako je rod u svojim temeljnim mehanizmima karakteriziran upravo glitchem, tehnologijom stalnog loma. „Razumijevanje roda kao u srži glitchastog, i transrodnosti kao nečega što tu glitchastost čini još očitijom, postavlja trans- u središte glitch feminizma i rodne teorije. Važno je da unutar ovakve strukture trans- nije samo modus kretanja kroz ili onkraj kategorija. Trans- radije predstavlja ključ razumijevanja roda kao mašinerije neuspjeha. Takva mašinerija roda povezuje rodna iskustva u povratne petlje čeznuća i žudnje.“
Je li nešto drugačije u načinu na koji roza figurira kao užitak ili njegovo naličje, žudnja, kod ljudi koji skliskost roda čine vidljivijom? Postavljam pitanje, ali ne mogu ponuditi odgovor, osim: vjerojatno ima više nijansi.
„Ružičasti oblak“, sintagma koja dolazi iz rječnika Alcoholics Anonymousa, koristi se za osjećaje sreće i euforije na početku rodne tranzicije, „kad je sve posve novo i predivno“. Mila Madison piše kako je za trans djevojke i žene on povezan s velikim prvim trenucima – prvi put kad nalakiraju nokte ili obuku neki komad odjeće ili im se netko obrati točnom zamjenicom. To, naravno, ne znači da je u činu lakiranja noktiju ili nošenja haljine sadržana ikakva esencija ženskosti – znači da patrijarhat diktira uvjete, prakse i simbole prihvatljive ženskosti, i da je za neke žene nepodudaranje s njom opasno po život, ali i da se u praksama ženskosti kriju užici, pa tako i užitak istraživanja mogućnosti vlastitog autentičnog postojanja. „Moći sve jasnije i jasnije vidjeti pravu sebe u ogledalu sa svakim novim danom“. Ružičasti je oblak euforija oslobođenja, ispunjenja žudnji, ali je, poput svake euforije, prolazan.
Devetogodišnja Avery Jackson pozira na naslovnici siječanjskog broja National Geographica o rodnoj revoluciji odjevena u ružičaste tajice i majicu, kose obojane u roza. Kao trans djevojčica, tako se izlaže brojnim kritikama, uključujući one o održavanju rodne binarnosti i manjku progresivnosti. „Poskliznula se na prvoj stepenici“, komentiraju transfobne feministkinje i spremno upiru prstom u rozu, koru banane. Svaki rodno normativan izbor uvijek je mnogo veći grijeh kad ga čini trans žena. Ne mogu interpretirati njenu žudnju ili užitak u rozoj u njeno ime, samo reći da na fotografiji Avery ružičastu vidim u obliku tisuća malih katana, tisuća malih ovacija, s velikim užitkom.
Pitanje naših žudnji i užitaka uvijek je, naravno, pitanje toga kako su ustrojene naša vlastita stabilnost i stvarnost, a ustrojene su klasom te rodom, dobi i ostalim identitetskim odrednicama, u sustavima koji proizvode i njih i njihova značenja, u mreži u kojoj smo čvor tih niti od kojih nas svaka povezuje sa svim ostalim, bližim i daljim, čvorovima na istoj niti. Nagla nesigurnost ili glitch jedne osobe za neku je drugu jedini tip stabilnosti koji poznaje. Odnosno, moj užitak i žudnja govore o meni kao osobi jednako koliko o mom položaju u mreži – ne samo kako i za čime žudim, nego i iz koje sam pozicije u poziciji žudjeti.
Osobno s rodom imam dosta pravocrtan odnos – ja sam cis žena, što znači da se moj rodni identitet poklapa s onime kako me drugi od rođenja doživljavaju – ali čim se probudim oblačim nevidljivu kutu s natpisom „Lana: žena“ i nastavljam neprestani proces svog orodnjavanja: doziranja, kalibriranja, temperiranja svakodnevnih izbora koji i meni i drugima komuniciraju moju ženskost. Tog sam procesa ponekad svjesna više, ponekad manje – roza je mjesto posebno opipljive svijesti o njemu. Dok žudim za rozom u formi odjeće, predmeta, hrane, pića, slika kojima se okružujem – dok je pokušavam akumulirati, odjenuti, progutati, upiti, inhalirati – znam da uvijek žudim i za rodom; nema pregovaranja s njenim značenjima van te stalne alkemije. Roza moju ženskost komunicira iskreno i ironično i ponekad subverzivno, ali u svakom je slučaju ne propušta komunicirati; pitanje je samo vide li drugi plošni stereotip ženskosti ili laboratorij roda. Ono za čime u srži žudim kad žudim za rozom i rodom vjerojatno je osjećaj dovršenosti, nekakvog konačnog ostvarenja. Da mogu sjesti, promotriti svoje djelo i otvoriti šampanjac. Ta je žudnja, ističe i Sundén, beznadna. Takva je i želja da stabiliziramo značenja roze i imamo je, napokon pribodenu na mjesto, lijepog mrtvog leptira.
ROZA KAO ESTETIKA
Roza, kao i sirene i jednorozi, već neko vrijeme proživljava svoj dan na suncu. Svi su isplivali iz zakutaka kulture kad su obalu počeli zauzimati milenijalci i trenutno su posvuda, blijedo-sedefaste naplavine. Radi se o specifičnoj nijansi roze, koja je od ranih 2010-ih it boja Tumblra i estetika dijela njegove djevojačke kulture, a preplavila je svijet nakon što su na nakupljenom potencijalu odlučili profitirati veliki igrači – Apple je 2015. izbacio iPhone tog valera, a Pantone ju je 2016. proglasio bojom godine. Zovemo je „millennial pink“, iliti „milenijski roza“.
Bacite kamen i pogodit ćete nešto milenijski roza, bacite drugi i pogodit ćete neki tekst posvećen njoj i njenoj pastelnoj prevlasti; Kevin Lo čitao ju je za Loki Design iscrpno i zanimljivo na fonu supkultura poput seapunka, za VoxFeminae je lani o njoj pisala Barbara Gregov, a vrlo temeljiti pregled njenog širenja zapadnim, tj. američkim svijetom dala je Lauren Schwartzberg za New York Magazine. U njemu se nalazi i nekoliko pjesničkih opisa nijanse: Eileen Myles procjenjuje da je „genital though not an excited one“, dok Patriciji Lockwood „looks like a pig who got scared“.
Poput svih pastelnih boja, milenijski roza lišena je strasti. Ona je nježna, smirena, spokojna: ne izgleda kao roza koja će vam provaliti u dvorište i obojati psa. Njena je nijansa taktika prigušivanja, gotovo umrtvljivanja, ali ne može izbrisati dvoličnu esenciju ružičastosti. Štoviše, ova ružičasta koja je najsličnija plijesni, nečemu pahuljastom a opasnom, tu esenciju možda i najbolje inkarnira. Neće obojati vašeg psa, uvjerit će vas da to učinite sami.
Što nam milenijski roza estetika govori o zeitgeistu? Aayesha A. Siddiqi na svom je Instagram profilu zimus komentirala da je roza posljednjih godina u trendu jer nas je „monokromatski athleisure oslobodio od pretpostavki o snazi u tamnom, ili u maskulinitetu – kao i vrlo mračni svijet, i novi oblici suočavanja sa starim nasiljem, s većom frekventošću. Odjednom izgledati meko nije bio rizik, očajnički smo to željeli. Kao i svi trendovi, impuls prema mekoći bio je potaknut emocijama i izražen teksturom“. Prema Siddiqi, koja također piše o američkom kontekstu, i referira se na aktualno rasističko nasilje i uzlet desnice, milenijski roza odlazi u prošlost, a budućnost donosi neonske boje i kamuflažne uzorke. Roza je bila oklop mekoće, omatanje u šećernu vunu da apsorbiramo gorčinu svijeta, ali „to nije odjeća kakvu biramo za kavgu“.
Schwartzberg tvrdi da s milenijski rozom roza gubi svoju „girly-girl prtljagu, sad je androgina“; nose je svi, a taj trend donose milenijalci, prva generacija koja odrasta uz sveprisutnost činjenice da se rod događa na spektru. U novom ironičnom obratu, roza – jedina boja koja može postati androgina, jer druge to već jesu – postaje glavna zvijezda rastakanja rodne binarnosti. Bojim se ipak da je njena općeprihvaćenost simptom trenda, pomodne ružičaste (g)roznice, i da se inicijalni DIY, antiseksistički, tumblrski djevojački impuls te estetike odavno isprao.
#Estetika tumblrskim jezikom označava stil, sadržaj, kolorit koji određena osoba ili grupa prepoznaje kao privlačan i rekreira. Jezikom filozofije, estetika je „znanost o osjetilnoj spoznaji“. Za mene, estetika roze je: rekreirati osjet svijeta kakav imam kad se dodirujemo na mjestima gdje je roza. Pisati ružičasto.
Moram završiti s ružama, od kojih je roza dobila ime (rosa, ruža, ružičasta). Zbližava ih i to što su u popularnoj svijesti skoro jednako omražene i susjede su u kulturnom imaginariju. Ruža je klišej, simbol plastične romantike i ljubavne i ostale neinspiriranosti. Ona je metonimija za ispraznost naših rituala i razotkriva nas kao životinje čopora; mislim da je to logika iza rečenice „mrzim ruže [bolji sam od vas. bolji sam od ruža]“. Ruža je žrtveno janje ljudske neinventivnosti, ali još više naše površnosti, jer nema ničega pogrešnog u ružinoj popularnosti: ruža ima na stotine i svijet nema puno stvari ljepših od ruža. Prijateljica i ja jednom smo u šetnji naišle na ružu nježne ljubičaste boje i bajnog mirisa, još uvijek je se sjetim. Latice s ruže na stolu jednom su mi pale u čašu vode i bila je to najukusnija čaša vode u mom životu. Prezir prema ruži promašen je, i malen i ljudski, sve što ruža nije. Kad je žrtvujemo, ružina krv ima okus ružičastog.
Osim toga, ruža nije oružje kakvo biraš za kavgu, ali može ti pustiti krv kad to najmanje očekuješ.
U feminističkoj povijesti, ruže simboliziraju one manje materijalne ciljeve borbe. U slavnoj rečenici feministkinje i sindikalistkinje Rose (!) Schneiderman, ono što tražimo kruh su i ruže – radnička prava, materijalna sigurnost, demontiranje sistema kapitalističke i patrijarhalne opresije, ali i pravo na zanos, za sve.
„Malo umjetnosti, ljubavi i ljepote njihove su izmučene duše znale
Da, za kruh se borimo – ali za ruže također sve bismo dale.“7
Mislim da je „previše ruža“ kritika s kojom se suočavamo – ili je osjećamo iza leđa – kao feministkinje primarno zaokupljene popularnom kulturom i dokolicom; kritika da je takav feminizam ružičast u pogrdnom smislu, mekan i naivan – kao da mislimo da je dovoljno samo to, da se patrijarhat ruši samo kroz promjene ideja, kroz (popularnu) kulturu i kroz naše svakodnevne sitnice. Naravno da ne, ali ruši se i kroz to, i u konačnici je manje važno što je obruč a što osovina kotača kad se ni bez jednog ne može ići naprijed. U svojim pisanim vrhuncima, od Rose Luxemburg preko Lorde do Ahmed, feminizam je investiran u slobodu i potencijal mišljenja. Ruku pod ruku s aktivističkim i političkim poslom, jer su nerazdvojni, feminizam je posao pažljivog slijeđenja misli krhkih kao vlas kose, posao dugog i teškog, kopačkog mišljenja, posao razmišljanja kao ronjenja na dah. Feminizam je i samotan, feminizam je i: sjedim i prebirem po stvarima koje stalno nosim u džepovima. I to razmišljanje o sitnicama ponekad jest luksuz, ali uvijek je i nužnost, jer minute svojih dana živimo u sitnicama. Prije svega ostalog, moramo znati svoje živote; nitko drugi neće. Bilo bi lijepo živjeti tisuće života kao roza, i nekad bih voljela biti boja, savršena i nedodirljiva i ničija, čak ni svoja, ali ne mogu. Ne mogu istovremeno govoriti kroz stotinu usta, samo kroz jedna, i ne mogu reći sve što bih trebala odjednom – prednost će uvijek imati moje najružičastije misli, i to je dovoljno.
- U radu “`Not just a colour’: pink as a gender and sexuality marker in visual communication”, objavljen u Visual Communication, 2008.
- Citiran u Koller.
- Citirana u Koller.
- Ovdje citiram Jo Paoletti prema knjizi Delusions of Gender Cordelije Fine.
- Citirana u radu Samanthe King.
- “Pink Diplomacy: On the Uses and Abuses of Breast Cancer Awareness”, Health Communication, 25: 286–289, 2010.
- Iz prijevoda pjesma Jamesa Oppenheima, koji je napisao pjesmu “Kruh i ruže” inspiriranu rečenicom Rose Schneiderman, prevela Asja Bakić.

:’)
“… makar me zanima koliko je zaista profitabilno takvo nepotrebno orodnjavanje robe.”
Izgleda da se isplati:
http://www.independent.co.uk/news/business/women-paying-more-than-men-for-everyday-product-thanks-to-unacceptable-gender-price-gap-a6820816.html
http://money.cnn.com/2016/03/07/pf/pink-tax/index.html
http://www.huffingtonpost.com/2014/11/20/pink-tax_n_6193952.html
izvrstan članak, uživala sam u čitanju!